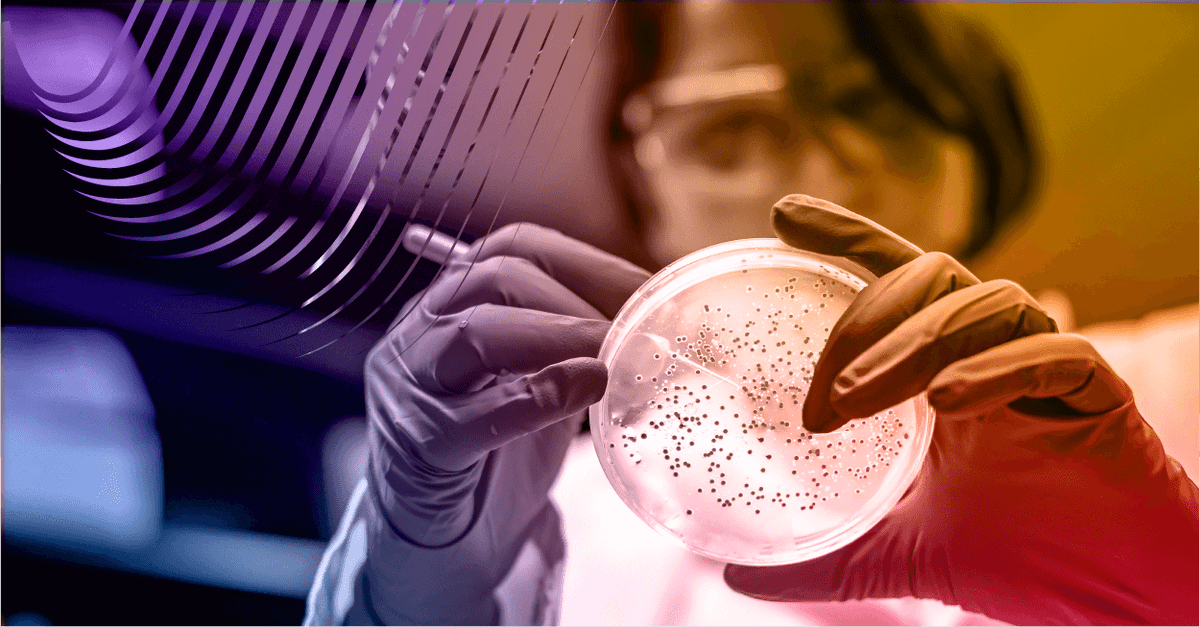
ABGi UK tweet media

Sabitlenmiş Tweet

🚨 If your year-end is 31/12/24 and you:
➡️ Haven’t claimed R&D tax relief before, or
➡️ Haven’t claimed in the last 3 years...
⚠️ you must pre-notify HMRC by 30/06/25 to stay eligible.
Miss it = no claim.
Check deadlines: shorturl.at/2ptMX
#RDTaxRelief #ABGiUK

English